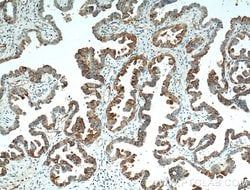
Img

50-173-6828
GATA3 Mouse anti-Human, Mouse, Clone: 1B11A8, Proteintech
Manufacturer: Proteintech Group Inc
Select a Size
| Pack Size | SKU | Availability | Price |
|---|---|---|---|
| Each of 1 | 50-173-6828-Each-of-1 | In Stock | ₹ 44,150.23 |
50-173-6828 - Each of 1
In Stock
Quantity
1
Base Price: ₹ 44,150.23
GST (18%): ₹ 7,947.041
Total Price: ₹ 52,097.271
Antigen
GATA3
Classification
Monoclonal
Concentration
1 mg/mL
Formulation
PBS with 50% glycerol and 0.02% sodium azide; pH 7.3
Gene Accession No.
P23771, P23772
Gene Symbols
Gata3
Immunogen
GATA3 Fusion Protein Ag0174
Quantity
150 μL
Primary or Secondary
Primary
Target Species
Human, Mouse
Product Type
Antibody
Isotype
IgG2a
Applications
Immunocytochemistry, Immunofluorescence, Immunohistochemistry (Paraffin), Western Blot
Clone
1B11A8
Conjugate
Unconjugated
Gene
GATA3
Gene Alias
GATA binding factor 3, GATA binding protein 3, GATA3, HDR
Host Species
Mouse
Purification Method
Protein A
Regulatory Status
RUO
Gene ID (Entrez)
14462, 2625
Content And Storage
-20°C
Form
Liquid
Description
- Trans-acting T-cell specific transcription factor GATA-3 is a member of GATA family of transcription factors that regulates development of multiple tissues
- It is an important transcription factor in regulating human Th2 cell differentiation in vivo.
Compare Similar Items
Show Difference
Antigen: GATA3
Classification: Monoclonal
Concentration: 1 mg/mL
Formulation: PBS with 50% glycerol and 0.02% sodium azide; pH 7.3
Gene Accession No.: P23771, P23772
Gene Symbols: Gata3
Immunogen: GATA3 Fusion Protein Ag0174
Quantity: 150 μL
Primary or Secondary: Primary
Target Species: Human, Mouse
Product Type: Antibody
Isotype: IgG2a
Applications: Immunocytochemistry, Immunofluorescence, Immunohistochemistry (Paraffin), Western Blot
Clone: 1B11A8
Conjugate: Unconjugated
Gene: GATA3
Gene Alias: GATA binding factor 3, GATA binding protein 3, GATA3, HDR
Host Species: Mouse
Purification Method: Protein A
Regulatory Status: RUO
Gene ID (Entrez): 14462, 2625
Content And Storage: -20°C
Form: Liquid
Antigen:
GATA3
Classification:
Monoclonal
Concentration:
1 mg/mL
Formulation:
PBS with 50% glycerol and 0.02% sodium azide; pH 7.3
Gene Accession No.:
P23771, P23772
Gene Symbols:
Gata3
Immunogen:
GATA3 Fusion Protein Ag0174
Quantity:
150 μL
Primary or Secondary:
Primary
Target Species:
Human, Mouse
Product Type:
Antibody
Isotype:
IgG2a
Applications:
Immunocytochemistry, Immunofluorescence, Immunohistochemistry (Paraffin), Western Blot
Clone:
1B11A8
Conjugate:
Unconjugated
Gene:
GATA3
Gene Alias:
GATA binding factor 3, GATA binding protein 3, GATA3, HDR
Host Species:
Mouse
Purification Method:
Protein A
Regulatory Status:
RUO
Gene ID (Entrez):
14462, 2625
Content And Storage:
-20°C
Form:
Liquid
Antigen: CALCOCO2
Classification: Monoclonal
Concentration: 1 mg/mL
Formulation: PBS with 50% glycerol and 0.02% sodium azide; pH 7.3
Gene Accession No.: A2A6M5, Q13137
Gene Symbols: Calcoco2
Immunogen: CALCOCO2 Fusion Protein Ag2866
Quantity: 150 μL
Primary or Secondary: Primary
Target Species: Human, Mouse, Rat
Product Type: Antibody
Isotype: IgG2a
Applications: Immunohistochemistry (Paraffin), Western Blot
Clone: 2F2C2
Conjugate: Unconjugated
Gene: CALCOCO2
Gene Alias: CALCOCO2, NDP52, Nuclear domain 10 protein 52, Nuclear dot protein 52
Host Species: Mouse
Purification Method: Protein A
Regulatory Status: RUO
Gene ID (Entrez): 10241, 303479, 76815
Content And Storage: -20°C
Form: Liquid
Antigen:
CALCOCO2
Classification:
Monoclonal
Concentration:
1 mg/mL
Formulation:
PBS with 50% glycerol and 0.02% sodium azide; pH 7.3
Gene Accession No.:
A2A6M5, Q13137
Gene Symbols:
Calcoco2
Immunogen:
CALCOCO2 Fusion Protein Ag2866
Quantity:
150 μL
Primary or Secondary:
Primary
Target Species:
Human, Mouse, Rat
Product Type:
Antibody
Isotype:
IgG2a
Applications:
Immunohistochemistry (Paraffin), Western Blot
Clone:
2F2C2
Conjugate:
Unconjugated
Gene:
CALCOCO2
Gene Alias:
CALCOCO2, NDP52, Nuclear domain 10 protein 52, Nuclear dot protein 52
Host Species:
Mouse
Purification Method:
Protein A
Regulatory Status:
RUO
Gene ID (Entrez):
10241, 303479, 76815
Content And Storage:
-20°C
Form:
Liquid
Antigen: TPRKB
Classification: Monoclonal
Concentration: 1 mg/mL
Formulation: PBS with 50% glycerol and 0.02% sodium azide; pH 7.3
Gene Accession No.: Q9Y3C4
Gene Symbols: TPRKB
Immunogen: TPRKB Fusion Protein Ag18770
Quantity: 150 μL
Primary or Secondary: Primary
Target Species: Human
Product Type: Antibody
Isotype: IgG1
Applications: Western Blot
Clone: 2D5B9
Conjugate: Unconjugated
Gene: TPRKB
Gene Alias: CGI 121, My019, PRPK binding protein, TP53RK binding protein, TPRKB
Host Species: Mouse
Purification Method: Protein G
Regulatory Status: RUO
Gene ID (Entrez): 51002
Content And Storage: -20°C
Form: Liquid
Antigen:
TPRKB
Classification:
Monoclonal
Concentration:
1 mg/mL
Formulation:
PBS with 50% glycerol and 0.02% sodium azide; pH 7.3
Gene Accession No.:
Q9Y3C4
Gene Symbols:
TPRKB
Immunogen:
TPRKB Fusion Protein Ag18770
Quantity:
150 μL
Primary or Secondary:
Primary
Target Species:
Human
Product Type:
Antibody
Isotype:
IgG1
Applications:
Western Blot
Clone:
2D5B9
Conjugate:
Unconjugated
Gene:
TPRKB
Gene Alias:
CGI 121, My019, PRPK binding protein, TP53RK binding protein, TPRKB
Host Species:
Mouse
Purification Method:
Protein G
Regulatory Status:
RUO
Gene ID (Entrez):
51002
Content And Storage:
-20°C
Form:
Liquid
Antigen: MSLN
Classification: Monoclonal
Concentration: 1 mg/mL
Formulation: PBS with 50% glycerol and 0.02% sodium azide; pH 7.3
Gene Accession No.: Q13421
Gene Symbols: MSLN
Immunogen: MSLN Fusion Protein Ag23606
Quantity: 150 μL
Primary or Secondary: Primary
Target Species: Human
Product Type: Antibody
Isotype: IgG1
Applications: Immunohistochemistry (Paraffin), Western Blot
Clone: 2E3A4
Conjugate: Unconjugated
Gene: MSLN
Gene Alias: CAK1, CAK1 antigen, mesothelin, MPF, MPF Mesothelin, cleaved form, MSLN, SMR
Host Species: Mouse
Purification Method: Protein G
Regulatory Status: RUO
Gene ID (Entrez): 10232
Content And Storage: -20°C
Form: Liquid
Antigen:
MSLN
Classification:
Monoclonal
Concentration:
1 mg/mL
Formulation:
PBS with 50% glycerol and 0.02% sodium azide; pH 7.3
Gene Accession No.:
Q13421
Gene Symbols:
MSLN
Immunogen:
MSLN Fusion Protein Ag23606
Quantity:
150 μL
Primary or Secondary:
Primary
Target Species:
Human
Product Type:
Antibody
Isotype:
IgG1
Applications:
Immunohistochemistry (Paraffin), Western Blot
Clone:
2E3A4
Conjugate:
Unconjugated
Gene:
MSLN
Gene Alias:
CAK1, CAK1 antigen, mesothelin, MPF, MPF Mesothelin, cleaved form, MSLN, SMR
Host Species:
Mouse
Purification Method:
Protein G
Regulatory Status:
RUO
Gene ID (Entrez):
10232
Content And Storage:
-20°C
Form:
Liquid